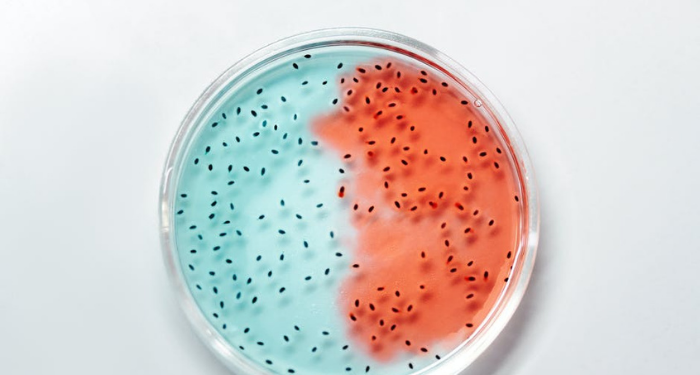
Sub Baru Varian Covid-19 XE, XD, dan XF

SEBUAH sub baru varian Covid-19 bernama XE, XD, dan XF terdeteksi di Inggris. Juru Bicara Vaksinasi Covid-19 Kementerian Kesehatan dr. Siti Nadia Tarmizi, M.Epid mengatakan bahwa sub varian XE merupakan gabungan dari genetik sub varian BA.1 dan BA.2.
Baca Juga: Indonesia Transisi Menuju Endemi Covid-19, MUFFEST+ 2022: Kami Tetap Disiplin Prokes
Sub Baru Varian Covid-19 XE, XD, dan XF
”Ini pertama kali terdeteksi dari spesimen pada tanggal 19 Januari di Inggris dan di sana sudah ada 763 kasus XE yang ditemukan,” katanya saat konferensi pers secara virtual di Jakarta, Selasa (12/4).
Sub varian XE dinilai lebih cepat menular dibandingkan sub varian BA.2. Namun, belum cukup bukti-bukti epidemiologis untuk memperlihatkan perubahannya di dalam masyarakat.
”Hingga saat ini baik sub varian XE, XD, maupun XF ini belum ditemukan di Indonesia,” ucap dr. Nadia.
Sementara itu, lanjut dr. Nadia, kalau sub varian XD dan XF adalah gabungan dari varian Delta AY.4 dan Omikron BA.1. Sub varian XF sudah ditemukan di Inggris tetapi masih sangat kecil jumlahnya.
”Artinya ini masih menjadi kewaspadaan kita bahwa walaupun dikatakan lebih cepat menular dibandingkan varian Omicron.
Tetapi karena kita sebagai bagian dari upaya menekan penularan dan memitigasi dampak daripada penularan tersebut, maka sub varian – sub varian ini menjadi perhatian kita bersama,” tutur Nadia.
Sampai saat ini, tidak ada perbedaan gejala khusus pada ketiga sub varian tersebut. Sub varian ini masih merupakan satu jenis yang sama dengan varian Omicron.
Walau belum terdeteksi di Indonesia, diimbau agar masyarakat tetap mematuhi protokol kesehatan yang ada.
Sahabat Muslim, mari jangan lengah karena virus Covid-19 belum sepenuhnya hilang. Semoga kita semua diberikan kesabaran dan kekuatan dalam menghadapi wabah ini. Aamiinn. [Cms]